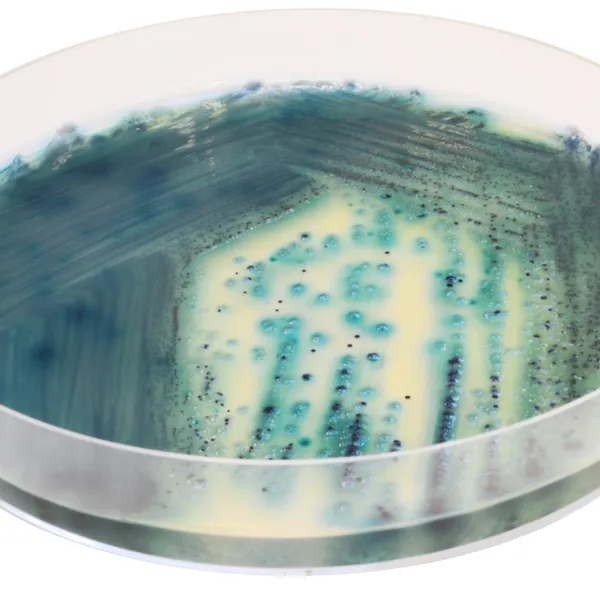
CHROMagar™ Pseudomonas

Hình thái khuẩn lạc

Pseudomonas bao gồm
P. aeruginosa

Hầu hết Enterobacteriaceae
màu tím nhạt đến tím hoặc bị ức chế
Hiệu năng
Hiệu năng
Pseudomonas là vi khuẩn phổ biến có mặt trong đất, trên thực vật, trong môi trường nước ngọt và biển. Nhiều chủng có thể phát triển ở nhiệt độ thấp (các chủng ưa lạnh) và có thể làm nhiễm bẩn thực phẩm hoặc sản phẩm dược phẩm được bảo quản trong tủ lạnh.
P. aeruginosa là một chỉ thị hợp lệ cho hiệu quả khử trùng nước giải trí. Thông số này hiện đang được sử dụng làm tiêu chí trong quy định về hồ bơi và bể bơi. Hơn nữa, P. aeruginosa không chỉ quan trọng bởi vai trò của nó là chỉ thị, mà còn vì nó là một tác nhân gây bệnh cơ hội mà sự lây truyền thường liên quan đến nước.
Các dạng khác của vi khuẩn Pseudomonas được biết là gây hư hỏng thực phẩm ở nhiệt độ thấp. Các chủng Pseudomonas ưa lạnh này bao gồm: P. fragi, gây hư hỏng sản phẩm từ sữa, P. taetrolens gây ẩm mốc trong trứng và P. mudicolens và P. lundensis, gây hư hỏng sữa, phô mai, thịt, và cá, nhưng hiếm khi là nguyên nhân gây ngộ độc thực phẩm.
1. Nhanh chóng : Từ 24 giờ ủ.
4. Dễ sử dụng : Khuẩn lạc có thể được quan sát dưới điều kiện ánh sáng bình thường. Khuẩn lạc Pseudomonas phát triển với màu xanh lam- xanh lục đậm, rõ ràng khi nhìn bằng mắt thường.
2. Phương pháp lọc : Một phương pháp lọc màng có thể được sử dụng để phát hiện từ 100 mL nước, màng đã được cấy sẽ được đặt lên đĩa thạch.
5. Dễ đọc :Một màu đậm độc đáo cho Pseudomonas.
3. Dễ chuẩn bị :Bột thạch đã được cân trước được trộn với lượng nước cất yêu cầu.
Thành phần

Tài liệu kỹ thuật
Công bố khoa học
2023
Spread of multidrug-resistant Pseudomonas aeruginosa in animal-derived foods in Beijing, China
📄 Publication2022
Evaluation of a Novel Chromogenic Medium for the Detection of Pseudomonas aeruginosa in Respiratory Samples from Patients with Cystic Fibrosis
📄 Publication

Xem thêm